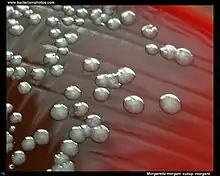

Morganella morganii
| Morganella morganii | |
|---|---|

| |
| Scientific classification | |
| Domain: | Bacteria |
| Kingdom: | Pseudomonadati |
| Phylum: | Pseudomonadota |
| Class: | Gammaproteobacteria |
| Order: | Enterobacterales |
| Family: | Morganellaceae |
| Genus: | Morganella Fulton, 1943 |
| Species: | M. morganii
|
| Binomial name | |
| Morganella morganii | |
| Subspecies | |
|
M. m. morganii | |
| Synonyms | |
| |
Morganella morganii is a species of Gram-negative bacteria.[2] It has a commensal relationship within the intestinal tracts of humans, mammals, and reptiles as normal flora.[2] Although M. morganii has a wide distribution, it is considered an uncommon cause of community-acquired infection, and it is most often encountered in postoperative and other nosocomial infections, such as urinary tract infections.[3]
Microbiology
Morganella morganii is facultatively anaerobic and oxidase-negative. Its colonies appear off-white and opaque in color, when grown on agar plates.[4] M. morganii cells are straight rods, about 0.6–0.7 μm in diameter and 1.0–1.7 μm in length. This organism moves by way of peritrichous flagella, but some strains do not form flagella at 30 °C (86 °F).[5]
M. morganii is split into two subspecies: M. morganii subsp. morganii and M. morganii subsp. sibonii.[6] M. morganii subsp. sibonii is able to ferment trehalose, whereas subsp. morganii cannot, and this is the primary phenotype used to differentiate them.[6]
M. morganii can produce the enzyme catalase, so it is able to convert hydrogen peroxide to water and oxygen. This is a common enzyme found in most living organisms. In addition, it is indole test-positive, meaning that this organism can split tryptophan to indole, pyruvate, and ammonia. M. morganii also produces urease, allowing it to break down urea.[7] Methyl red tests positive in M. morganii, an indicator dye that turns red due to the bacterium's acid production during fermentation.[4]
History
Morganella morganii was first described by a British bacteriologist H. de R. Morgan in 1906 as Morgan's bacillus. Morgan isolated the bacterium from stools of infants who were noted to have had "summer diarrhea".[8] Later in 1919, Winslow et al. named Morgan's bacillus, Bacillus morganii. In 1936, though, Rauss renamed B. morganii as Proteus morganii. Fulton, in 1943, showed that B. columbensis and P. morganii were the same and defined the genus Morganella, due to the DNA-DNA hybridization.[9] In 1943, Fulton attempted to define a subspecies, M. m. columbensis.[6] However, in 1962, a review article by Ewing reported that M. columbensis had been re-identified as Escherichia coli, thereby removing that organism from the genus Morganella.[6]
Infection

Although a rare human pathogen, M. morganii has been reported as a cause of urinary tract infections, nosocomial surgical wound infections, peritonitis, central nervous system infection, endophthalmitis, pneumonia, chorioamnionitis, neonatal sepsis, pyomyositis, necrotizing fasciitis, and arthritis. Numerous cases of nosocomial infection have been described, usually as postsurgical wound infections or urinary tract infections. Patients in whom bacteremia develops are typically immunocompromised, diabetic, or elderly, or have at least one serious underlying disease. M. morganii has been regarded as a normally harmless opportunistic pathogen, but some strains carry "antibiotic-resistant plasmids" and have been associated with nosocomial outbreaks of infections.[10] Several reports indicate M. morganii causes sepsis, ecthyma, endophthalmitis, and chorioamnionitis, and more commonly urinary tract infections, soft tissue infections, septic arthritis, meningitis, and bacteremia, in the latter 2 cases with frequent fatal consequences.[11]
In a rare case published in 2003, a patient presented with bilateral necrosis of both upper and lower eyelids. Upon microbial analysis, the areas were shown to have heavy growth of M. morganii.[12]
Treatment
Treatment of M. morganii infections may include:
- Ticarcillin
- Piperacillin
- Ciprofloxacin
- Third-generation and fourth-generation cephalosporins
A study conducted at the University Hospital at Heraklion, Crete, Greece, showed a 92% success rate in the use of these antibiotics.[13]
However, some M. morganii strains are resistant to penicillin, ampicillin/sulbactam, oxacillin, first-generation and second-generation cephalosporins, macrolides, lincosamides, fosfomycin, colistin, and polymyxin B.[3] The emergence of highly resistant strains of M. morganii have been associated with use of third-generation cephalosporins.[3]
Polymicrobial infections are most abundantly caused by this microbe which additionally damages the skin, soft tissues, and urogenital tract; these can be cured through use of the aforementioned antibiotics.[13]
References
- ↑ 1.0 1.1 UniProt. Morganella morganii (Proteus morganii) Archived 4 May 2022 at the Wayback Machine
- ↑ 2.0 2.1 eMedicine. Morganella infections Archived 28 May 2023 at the Wayback Machine
- ↑ 3.0 3.1 3.2 "Morganella infections". Medscape. Archived from the original on 25 November 2012. Retrieved 5 December 2012. Archived 28 May 2023 at the Wayback Machine
- ↑ 4.0 4.1 Herrara, Jose. "Morganella morganii". Truman State University Biology. Truman State University. Archived from the original on 13 December 2012. Retrieved 6 December 2012. Archived 13 December 2012 at the Wayback Machine
- ↑ "Morganella morganii". University of Windsor. Archived from the original on 4 February 2014. Retrieved 6 December 2012. Archived 4 February 2014 at the Wayback Machine
- ↑ 6.0 6.1 6.2 6.3 O'Hara CM, Brenner FW, Miller JM (13 October 2000). "Classification, identification, and clinical significance of Proteus, Providencia, and Morganella". Clinical Microbiology Reviews. 4. 13 (4): 534–546. doi:10.1128/cmr.13.4.534-546.2000. PMC 88947. PMID 11023955.
- ↑ Hu, L T; Nicholson, E B; Jones, BD; Lynch, MJ; Mobley, HL (June 1990). "Morganella morganii urease: purification, characterization, and isolation of gene sequences". J Bacteriol. 172 (6): 3073–80. doi:10.1128/jb.172.6.3073-3080.1990. PMC 209110. PMID 2345135.
- ↑ Pulaski, E. J.; Deitz, G. W. (1940). "Morgan's bacillus septicemia". Journal of the American Medical Association. 115 (11): 922. doi:10.1001/jama.1940.72810370001008. ISSN 0002-9955.
- ↑ Chen, Yu-Tin; Peng, Hwei-Ling; Shia, Wei-Chung; Hsu, Fang-Rong; Ken, Chuian-Fu; Tsao, Yu-Ming; Chen, Chang-Hua; Liu, Chun-Eng; Hsieh, Ming-Feng; Chen, Huang-Chi; Tang, Chuan-Yi; Ku, Tien-Hsiung (2012). "Whole-genome sequencing and identification of Morganella morganii KT pathogenicity-related genes". BMC Genomics. 13 (Suppl 7): S4. doi:10.1186/1471-2164-13-S7-S4. ISSN 1471-2164. PMC 3521468. PMID 23282187.
{{cite journal}}: CS1 maint: unflagged free DOI (link) - ↑ Senior, W; S. Voros (1990). "Protein profile typing--a new method of typing Morganella morganii strains" (PDF). Journal of Medical Microbiology. 33 (4): 259–264. doi:10.1099/00222615-33-4-259. PMID 1701835. Archived from the original (PDF) on 4 September 2011. Retrieved 6 December 2012. Archived 4 September 2011 at the Wayback Machine
- ↑ Singla, Nidhi; Neelam Kaistha; Neelam Gulati; Jagdish Chander (July–September 2010). "Morganella morganii could be an important intensive care unit pathogen". Indian Journal of Critical Care Medicine. 14 (3): 154–155. doi:10.4103/0972-5229.74176. PMC 3021833. PMID 21253351.
{{cite journal}}: CS1 maint: unflagged free DOI (link) - ↑ Shenoy MD; AU Shenoy; AM Rajay; ZH al Mahrooqui (2003). "Necrotic Periorbital Ulceration due to Morganella morganii" (PDF). Asian Journal of Ophthalmology. 1. 5. Archived from the original (PDF) on 2 February 2014. Retrieved 10 December 2012. Archived 2 February 2014 at the Wayback Machine
- ↑ 13.0 13.1 Falagas, M.E.; P.K. Kavvadia; E. Mantadakis; D.P. Kofteridis; I.A. Bliziotis; E. Saloustros; S. Maraki; G. Samonis (2006). "Morganella morganii infections in General Tertiary Hospital". Clinical and Epidemiology Study. 34 (6): 315–321. doi:10.1007/s15010-006-6682-3. PMID 17180585. S2CID 6599259.
Further reading
- De, A; Raj, HJ; Maiti, PK (2016). "Biofilm in osteomyelitis caused by a rare pathogen, Morganella morganii: A case report". Journal of Clinical and Diagnostic Research. 10 (6): DD06 – DD08. doi:10.7860/JCDR/2016/18666.7990. PMC 4963648. PMID 27504288 – via Elsevier Science Direct.
- Emborg, J; Dalgaard, P (2008). "Growth, inactivation and histamine formation of Morganella psychrotolerans and Morganella morganii - development and evaluation of predictive models". International Journal of Food Microbiology. 128 (2): 234–243. doi:10.1016/j.ijfoodmicro.2008.08.015. PMID 18845350 – via Elsevier Science Direct.
- Hu, LT; Nicholson, EB; Jones, BD; Lynch, MJ; Mobley, HLT (1990). "Morganella morganii urease: Purification, characterization, and isolation of gene sequences". Journal of Bacteriology. 172 (6): 3073–3080. doi:10.1128/jb.172.6.3073-3080.1990. PMC 209110. PMID 2345135 – via Elsevier Science Direct.
- Lee, IK; Liu, JW (2006). "Clinical characteristics and risk factors for mortality in Morganella morganii bacteremia". Journal of Microbiology, Immunology, and Infection. 39 (4): 328–334. PMID 16926980 – via Elsevier Science Direct.
- Liu, H; Zhu, J; Hu, Q; Rao, X (2016). "Clinical characteristics and risk factors for mortality in Morganella morganii bacteremia". International Journal of Infectious Diseases. 50: 10–17. doi:10.1016/j.ijid.2016.07.006. PMID 27421818 – via Elsevier Science Direct.
- Özoğul, F (2004). "Production of biogenic amines by Morganella morganii, Klebsíella pneumoniae and Hafnia alvei using a rapid HPLC method". European Food Research and Technology. 219 (5): 465–469. doi:10.1007/s00217-004-0988-0. S2CID 84860663 – via Elsevier Science Direct.
- Parikh, RY; Ramanathan, R; Coloe, PJ; Bhargava, SK; Patole, MS; Shouche, YS; Bansal, V (2011). "Genus-wide physicochemical evidence of extracellular crystalline silver nanoparticles biosynthesis by morganella spp". PLoS ONE. 6 (6): e21401. Bibcode:2011PLoSO...621401P. doi:10.1371/journal.pone.0021401. PMC 3119697. PMID 21713008 – via Elsevier Science Direct.
- Rojas, L; Vinuesa, T; Tubau, F; Truchero, C; Benz, R; Viñas, M (2006). "Integron presence in a multiresistant Morganella morganii isolate". International Journal of Antimicrobial Agents. 27 (6): 502–512. doi:10.1016/j.ijantimicag.2006.01.006. PMID 16690260 – via Elsevier Science Direct.</ref>Stock, I; Wiedemann, B (1998). "Identification and natural antibiotic susceptibility of Morganella morganii". Diagnostic Microbiology and Infectious Disease. 30 (3): 153–165. doi:10.1016/S0732-8893(97)00243-5. PMID 9572021 – via Elsevier Science Direct.
External links
- Type strain of Morganella morganii at BacDive - the Bacterial Diversity Metadatabase Archived 17 September 2016 at the Wayback Machine